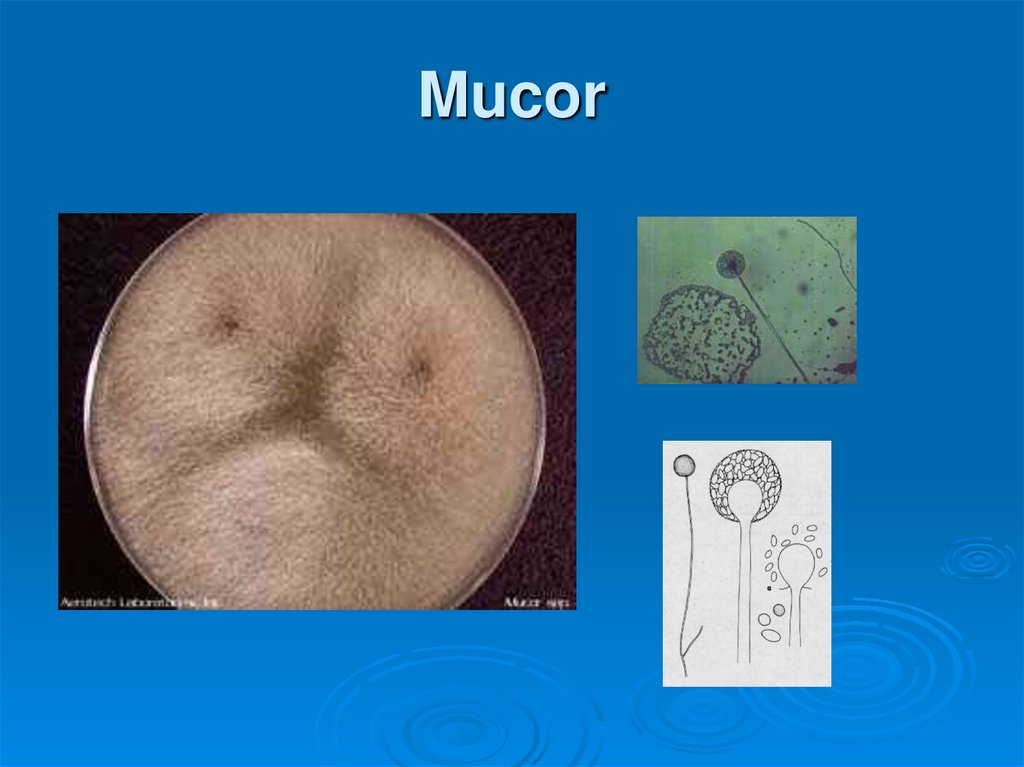
Mucor

Похожие презентации:
Грибы. Царство настоящие грибы – Mycota (Fungi)
1. ГРИБЫ
2. Царство настоящие грибы – Mycota (Fungi)
Отдел Хитридиомикота- ChytridiomycotaКласс Хитридиомицеты Сhytridiomycetes
3. Чёрная ножка капусты
Облигатный внутриклеточный паразитЗаражает молодые растения
Необходима повышенная влажность
Корневая шейка размягчается, чернеет,
ткань загнивает
Растения теряют тургор, желтеют,
погибают
4. Рак картофеля
Облигатный внутриклеточный паразитЗаражает молодые растения
Необходима повышенная влажность
На клубнях бугристые наросты в виде
губки
Наросты значительно превышают
размер самих клубней
Постепенно буреют, чернеют и
распадаются
5. Чёрная ножка капусты-Olpidium brassicae
Чёрная ножка капустыOlpidium brassicae6. Рак картофеля –Synchytrium endobioticum
Рак картофеля –Synchytrium endobioticum
7. Рак картофеля
8. Отдел Зигомикота - Zygomycota
Почти все представители ведут наземныйобраз жизни
Сапротрофы и паразиты
Зигогамия
У большинства мицелий гетероталличный
9. Класс зигомицеты
Пор. Мукоровые –Mucorales
Плесневые грибы –
на загнивающих
пищевых продуктах
Р. Mucor – плесень
овощей и пищевых
продуктов
Р.Rhizopus - черная
плесень на хлебе
Пор.
Энтомофторовые –
Entomophthorales
P. Entomophthora –
вызывает гибель
насекомых
Узко
специализированы
по отношению к
отдельным видам
насекомых
10. Mucor
11. Rhizopus
12. Rhizopus
13. Entomophthora
14. Отдел Аскомикота (Ascomycota) или Сумчатые грибы
Кл. Археаскомицеты ArchaeascomycetesКл. Голосумчатые – Hemiascomycetes
Кл. Настоящие сумчатые –Ascomycetes
Кл. Локулоаскомицеты Loculoascomycetes
15. Класс Археаскомицеты
Пор. Сахаромицетовые –Saccharomycetales
В основном сапротрофы
Сем. Сахаромицетовые –
Saccharomycetaceae
дрожжи
Пор. ТафриновыеTaphrinales
P. Taphrina – облигатные
узкоспециализированные
патогены
T. deformans –курчавость
листьев персика
T. pruni – кармашки слив
T. cerasi – «ведьмина
метла»
16. «Кармашки слив» Taphrina pruni
Поражаютсязавязи, из которых
формируются
уродливые плоды
мешковидной
формы без
косточки
Поверхность
пораженных
плодов
покрывается
17. «Кармашки слив»
18. Курчавость листьев персика Taphrina deformans
Поражаютсялистья и побеги
весной
Молодые листья
имеют желтоватую
или краснорозовую окраску,
деформируются
Больные листья по
размеру больше
здоровых
19. Курчавость листьев персика
20. Курчавость листьев персика
21. «Ведьмина метла» на вишне Taphrina cerasi
На деревьяхпоявляются
тонкие, хилые,
скученно
расположенные
побеги,
напоминающие
метлу
Листья на
пораженных
побегах мелкие
бледно-зеленые

Биология
Биология








